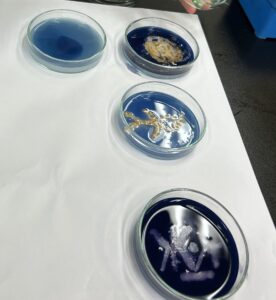

学園祭レポートTTCフェスティバル2025 (バイオテクノロジー科)

【6年ぶりの開催!TTCフェスティバル2025】
2025年10月25日、6年ぶりとなるTTC学園祭が開催されました。 あいにくの小雨模様となりましたが、6年ぶりに実現した学園祭に、学生たちは雨に負けない熱意をもって臨みました。
本学園祭にご来場いただいた高校生、卒業生、在学生のご家族、近隣の皆様など、総勢270名の皆様に心より感謝申し上げます。




【バイオテクノロジー科の活動紹介】
バイオテクノロジー科では、RJP(リアルジョブプロジェクト)活動を紹介する展示と体験ブースを開催しました。
アクアポニックス班は、手動卓上錠剤形成機を使った、ラムネ作り体験コーナー。技術を応用したユニークな体験が大人気でした。


キノコ班は、微生物の白金耳を使った植菌体験!(実際は、微生物は使わず胃薬を使ってお絵描き)実習で行う「画線培養」の気分を味わってもらいました。

水耕栽培班は、水菜やダイコンの水耕栽培を展示し、遺伝子調和型農業という新しい栽培法について紹介しました。来場者にとって、未来の農業を考える機会となりました。

クラフトコーラ班は、コーラづくりに使うさまざまな香辛料を香りであてるクイズを実施。見学者は、コーラ作りの奥深さに驚いていました。
パン班は、11:30~と14:00~の2回、時短パン教室を開催。パンが焼きあがるいい香りは、他の階まで広がり、来場者の皆様の食欲を刺激したようです。参加者の弾けるような笑顔が印象的でした。


味噌班は、「焼き餅」模擬店を開店!あんこ、醤油、味噌、きなこの4種類の味が並び、お客様が絶え間なく訪れる大繁盛ぶりでした。焦げ目のついた焼き餅は、雨模様の肌寒い日にぴったりの温かい一品。学生たちもテキパキと対応し、大忙しの一日でした。


【学園祭のフィナーレを飾った「同窓会」】
学園祭終了後には、本校学生ホールで同窓会が開催されました。70名以上の卒業生が一堂に会し、久しぶりの再会に思い出話で盛り上がりました。バイオテクノロジー科の卒業生も16名が参加してくれ、私たち教員に近況を聞かせてくれました。みなさん充実した日々を過ごしているようで、教員一同とても嬉しいです!




学生たちの笑顔と、来場者の皆様の温かいご声援のおかげで、楽しい学園祭になりました!
来年の学園祭もどうぞご期待ください。
文責)宮ノ下いずる【186】